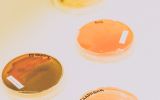

Aktualności
Szósta edycja Nocy Biologów za nami
![EO9A7764.jpg [1.66 MB]](files/ur/import/private/16/noc-biologow-2022/EO9A7764.jpg)
14 stycznia odbyła się VI edycja Nocy Biologów. Ze względu na obowiązujące ograniczenia spotkania odbywały się w formie hybrydowej.
W przestrzeni wirtualnej wykorzystano platformę ZOOM, media społecznościowe (Facebook, YouTube) oraz quizy interaktywne. W tym samym czasie , w formie tradycyjnej odbywały się wykłady i warsztaty (blisko 60 dotyczących 25 różnorodnych zagadnień), pokazy otwarte, wystawy przyrodnicze, gry i zabawy edukacyjne (8 pozycji z kilkoma wariantami do prezentacji).
Wartym podkreślenia jest fakt, że do przygotowania i współprowadzenia pokazów, warsztatów i wystaw oraz dokumentowania wydarzeń w ramach Nocy Biologów czynnie zaangażowało się blisko 70 studentów (46 studentów Biologii, 14 studentów Biotechnologii, 1 student Rolnictwa oraz 6 studentów reprezentujących koło fotograficzne LENS).
Zapraszamy na foto i video relacje z wydarzenia zapraszając jednocześnie na kolejne.
Zdjęcia – Michał Święcicki/UR
Video – Bartosz Babelski/UR i Joanna Wilk/UR oraz Kornelia Grabowska